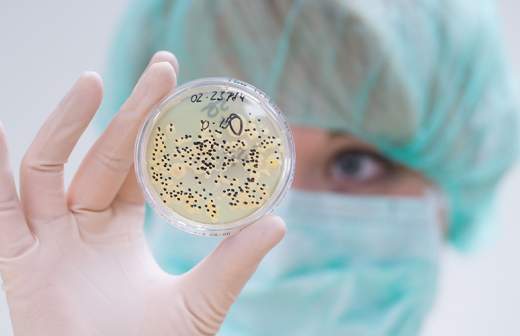

По горячим следам: теплолюбивый микроб с Камчатки переработает отходы

Специалисты НИЦ «Курчатовский институт» провели расшифровку генома термофильной бактерии Caldanaerobacter sp. 1523vc, найденной в природном горячем ключе на Камчатке. Эти микроорганизмы приспособились к жизни в среде с высокой температурой. В источнике, где был найден новый штамм, она составляет 70 градусов по Цельсию. В ходе анализа генома Caldanaerobacter sp. ученые выявили уникальные гены, кодирующие ферменты углеводного обмена, с помощью которых можно расщеплять биомассу и полимеры. На основе этих ферментов можно создавать новые моющие средства, расщеплять древесину и растительную биомассу для получения топлива, очищать промышленные стоки от токсичных металлов и радионуклидов, получать биогаз, а также использовать их для интенсификации технологических процессов в сельском хозяйстве, текстильной, пищевой, целлюлозно-бумажной, фармацевтической промышленности.
За микробом на край света
Данные, что на Камчатке существуют термофильные микроорганизмы, были получены довольно давно. За счет вулканической активности вода в местных источниках разогревается до температуры кипения и насыщается веществами, на первый взгляд, не совместимыми с жизнью. Но именно в таких тяжелых условиях наиболее комфортно чувствуют себя экстремофильные бактерии, в число которых входят и термофилы. Разнообразие этих микроорганизмов очень велико, и до недавнего времени было известно лишь порядка 1% от всех экстремофилов. Ученым удалось построить гипотезу о том, в какой питательной среде могут расти и размножаться такие бактерии. К тому же они располагали данными о других микроорганизмах того же вида, что и Caldanaerobacter sp.
— Изучение термофильных организмов — интересная и актуальная тема, дающая как фундаментальные, так и прикладные результаты. Нам важно найти источник термостабильных ферментов, открыть организмы, которые будут эффективно перерабатывать сырье и превращать его в нужные нам продукты, — говорит лаборант НИЦ «Курчатовский институт» Алексей Корженков.
Одна из наиболее успешных экспедиций на кальдеру Узон, где обнаружили Caldanaerobacter sp., была проведена в сентябре 2005 года учеными из Института микробиологии им. С.Н. Виноградского. На семь дней исследователи поместили емкости с различными полимерными субстратами непосредственно в источник. За это время были накоплены значительные количества микроорганизмов, образующихся на определенных субстратах. Бактерия, изначально выделенная на льняном материале, в дальнейшем была культивирована на целлюлозе. Уже в лаборатории удалось идентифицировать ее как представителя рода Caldanaerobacter.
Многие микроорганизмы, обнаруженные на Камчатке, обладают общей родословной с бактериями из горячих источников американского Йеллоустоуна и Исландии. Несмотря на значительное число работ ученых из Азии, США остаются мировым лидером по изучению и прикладному использованию термофильных микроорганизмов.
— Россия благодаря уникальной географии и серьезной научной базе может выйти в лидеры по изучению и применению термофильных бактерий, — говорит Алексей Корженков. — Кроме Камчатки горячие источники, где они обитают, есть на Кавказе, в Якутии и Тыве. Эти микроорганизмы могут стать таким же ценным природным ресурсом, как углеводороды, ведь их можно использовать в высокотехнологичном производстве, биоэнергетике и биомедицине.
Поймать бактерию
— Термофильные бактерии, к которым относится и Caldanaerobacter sp., один из наиболее перспективных источников ферментов и других молекул для биотехнологии, — рассказал «Известиям» начальник отдела биотехнологий и биоэнергетики Курчатовского комплекса НБИКС-технологий НИЦ «Курчатовский институт» Раиф Василов. — Наибольший интерес ученых сейчас вызывают ферменты углеводного обмена. Их ценность в том, что они способны расщеплять биомассу и другие полимеры. Гены, кодирующие их, и были выявлены в ходе исследования бактерии с Камчатки. Потенциально это может привести к получению новых биотехнологических продуктов для широкого применения.
Наиболее известным примером практического использования термофильных бактерий можно назвать применение ферментов, выделенных из них, в моющих средствах, рынок которых огромен, рассказывает эксперт.
По его словам, сейчас во всем мире идут поиски ферментов для эффективного расщепления древесины и растительной биомассы, чтобы получать из непищевого сырья биотопливо второго поколения. А создание экономически конкурентоспособных и экологически чистых технологий получения сахаров из биомассы откроет новые возможности для производства продовольствия, кормов, топлива и химикатов.
Термофильные микроорганизмы используются также для биогидрометаллургического выщелачивания руд, очистки промышленных стоков от токсичных металлов и радионуклидов, получения биогаза путем переработки органических отходов и т.д.
Кроме того, эти термостабильные ферменты могут найти применение в молекулярной биологии и медицинской диагностике — например, в полимеразной цепной реакции (ПЦР) с использованием термостабильных ДНК-полимераз и лигаз. Также можно использовать различные термостабильные ферменты для интенсификации технологических процессов в сельском хозяйстве, текстильной, пищевой, целлюлозно-бумажной, фармацевтической промышленности, рассказал эксперт.
Уникальные гены
— Сбор образцов из уникальных мест и геномный анализ содержащихся в них видов — очень важная область исследований, — рассказал «Известиям» Алексей Комиссаров, ведущий научный сотрудник химико-биологического кластера Университета ИТМО. — Каждый новый геном уникален сам по себе и содержит много новых редких генов, которые мы можем использовать для решения биотехнологических задач. Работа с такими немодельными видами значительно сложней, чем с обычными модельными бактериями, такими как кишечная палочка.
Специалист отметил, что авторы исследования сделали акцент на ферментах, участвующих в синтезе, метаболизме и распознавании сложных углеводов. Эти ферменты могут быть использованы для расширения арсенала доступных молекулярно-биологических инструментов. Но это только верхушка айсберга: каждый такой геном содержит много других новых генов, которые только предстоит найти будущим исследователям, особенно тем, которые используют методы сравнительной геномики.
— Использование бактерий, которые не погибают при экстремальных температурах, — это наиболее прикладной аспект данного исследования. Ученые смогут воспроизвести элементы генома этих бактерий, которые кодируют именно высокотемпературные ферменты. Они будут эффективно «разрезать» целлюлозу, что поможет, например, существенно сокращать мусорные свалки, — говорит Игорь Радченко, директор научного центра «RASA-Политех» Санкт-Петербургского политехнического университета Петра Великого.
Эксперт считает, что в будущем эту технологию возможно будет модифицировать для разработки бактерий для борьбы с пластиковым мусором.